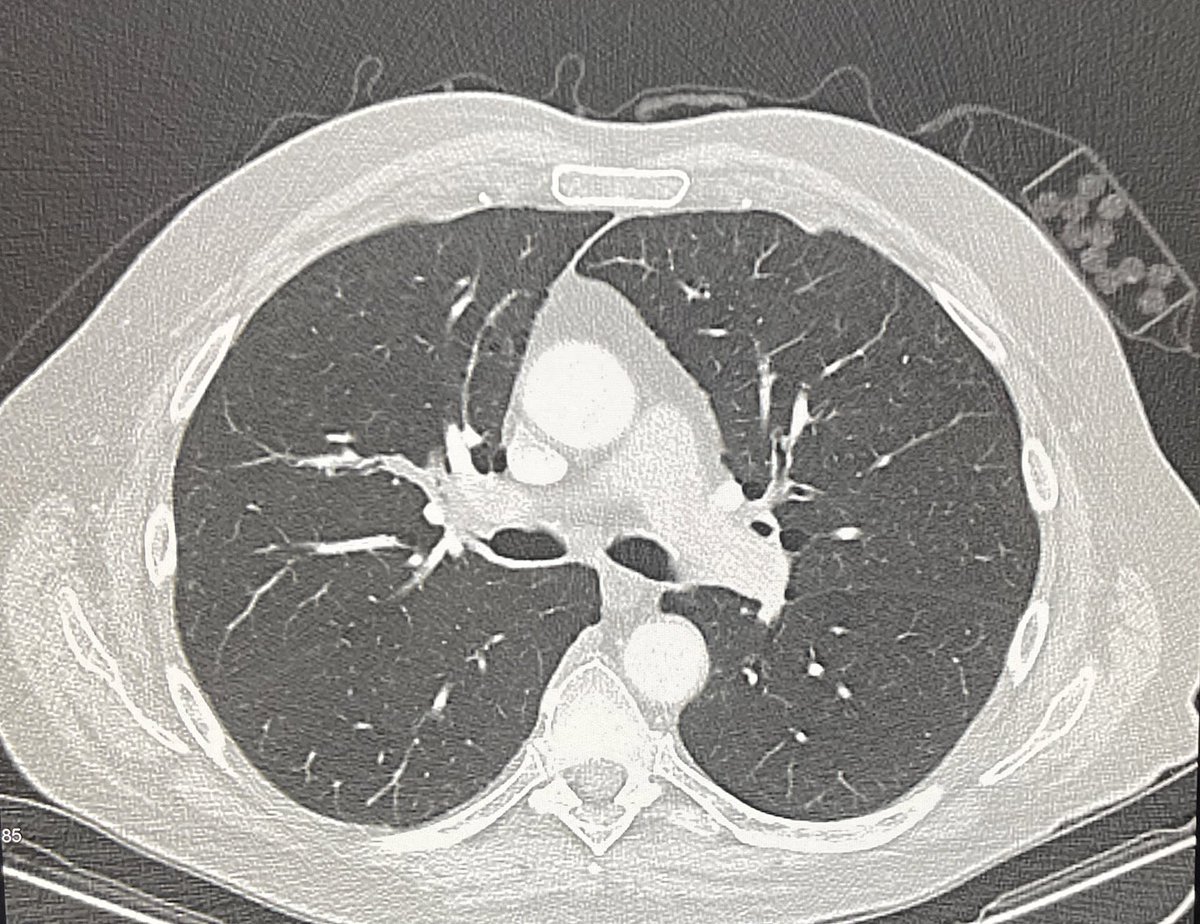
DrFranckClarot's tweet image. Quand la cause est immédiatement visible au scanner 🤔🤓

Will
@aero_will
Commercial Pilot (Frozen ATPL(A) / CPL(H)) 🛫🚁 //#Avgeek // Photo de bannière : @benjamin_video
คุณอาจชื่นชอบ
Je laisse les accidents de la route à Sudpresse mais là, WOW.




Les masques à oxygène sur Airbus sont faits pour être mis rapidement, à une main. Ici par contre, le pilote n’a pas à se battre avec son casque d’écoute (headset)
Et voici une des premières photos du déplacement latéral de la plaque anatolienne vs arabique suite au séisme de Kahramanmaras. 3 mètres ! Énergie énorme, conséquences énormes 😢 #sismologie

OK let's try this again, ordering a nothing burger from McDonalds. this time nothing else in the order. will they cancel it? deliver an empty bag? i am doing this so you don't have to

If you ever see someone with a telescope on the sidewalk, please come bother them. Nothing pleases me more than watching the reaction of someone seeing a planet with their own eyes for the first time.

Le crash le plus nul de l’histoire des crashs
Flash - Un jet #F35B s’est écrasé sur la piste d’atterrissage de la base navale de #FortWorth au Texas
Donc la grève est aussi lundi @GroupeSNCF @SNCFVoyageurs @SNCF ? Et on me prévient à 20:03 comme ça pas d’assistance téléphonique possible… Vous me faites définitivement préférer l’avion !

Nostalgia on film (open to see more)




This is what engineers do when they get bored out of programming... 🙂
Pas Anne.
Avec quel personnage de série vous aimeriez être en colocation ?
Any guesses which European destination I’ve flown to today? If you know you know 😋

Quand la cause est immédiatement visible au scanner 🤔🤓
⛈ Outre l'est de la France, les violents orages de #grêle ont également impacté la #Suisse hier 20 juillet 2022. Images impressionnantes de grêlons tombant sur le lac de Thoune. (via @jasi91362366)
United States เทรนด์
- 1. FINALLY DID IT 901 B posts
- 2. The PENGU 239 B posts
- 3. The Jupiter 306 B posts
- 4. The BONK 171 B posts
- 5. Iran 1,22 Mn posts
- 6. #LetterboxdWrapped 1.011 posts
- 7. Mamdani 636 B posts
- 8. #ThankYouTrump 23,3 B posts
- 9. Texas State 18,3 B posts
- 10. Communism 64,4 B posts
- 11. Robertson 9.171 posts
- 12. #FursuitFriday 11,4 B posts
- 13. #FanCashDropPromotion 3.355 posts
- 14. #tremendous 4.897 posts
- 15. Max Payne N/A
- 16. Avery Johnson N/A
- 17. Trocheck 2.025 posts
- 18. Nelson 16,1 B posts
- 19. Dilbert 4.632 posts
- 20. Brad Jackson N/A
คุณอาจชื่นชอบ
-
 Gauthier ✈️✈️
Gauthier ✈️✈️
@FlyingGauthier -
 Nicolas
Nicolas
@Nicolas_AFR -
 Fleur
Fleur
@floupilote -
 Willem
Willem
@will_gvl -
 Cameron PPL Frustré
Cameron PPL Frustré
@F_GAHX -
 Christophe MILIAN
Christophe MILIAN
@FlyingToToF -
 Guillaume Bechu
Guillaume Bechu
@guibechu -
 Gordon Shumway
Gordon Shumway
@gordonmelmac -
 Titouan
Titouan
@TS_aero -
 eliottisflying
eliottisflying
@eliottisflying -
 Le Pilote
Le Pilote
@Lepilote11 -
 Fabprotw
Fabprotw
@Fabprotw -
 Louis
Louis
@louis_truc14 -
 Diamond Pilot
Diamond Pilot
@DiamondPilotFr
Something went wrong.
Something went wrong.
























































































































